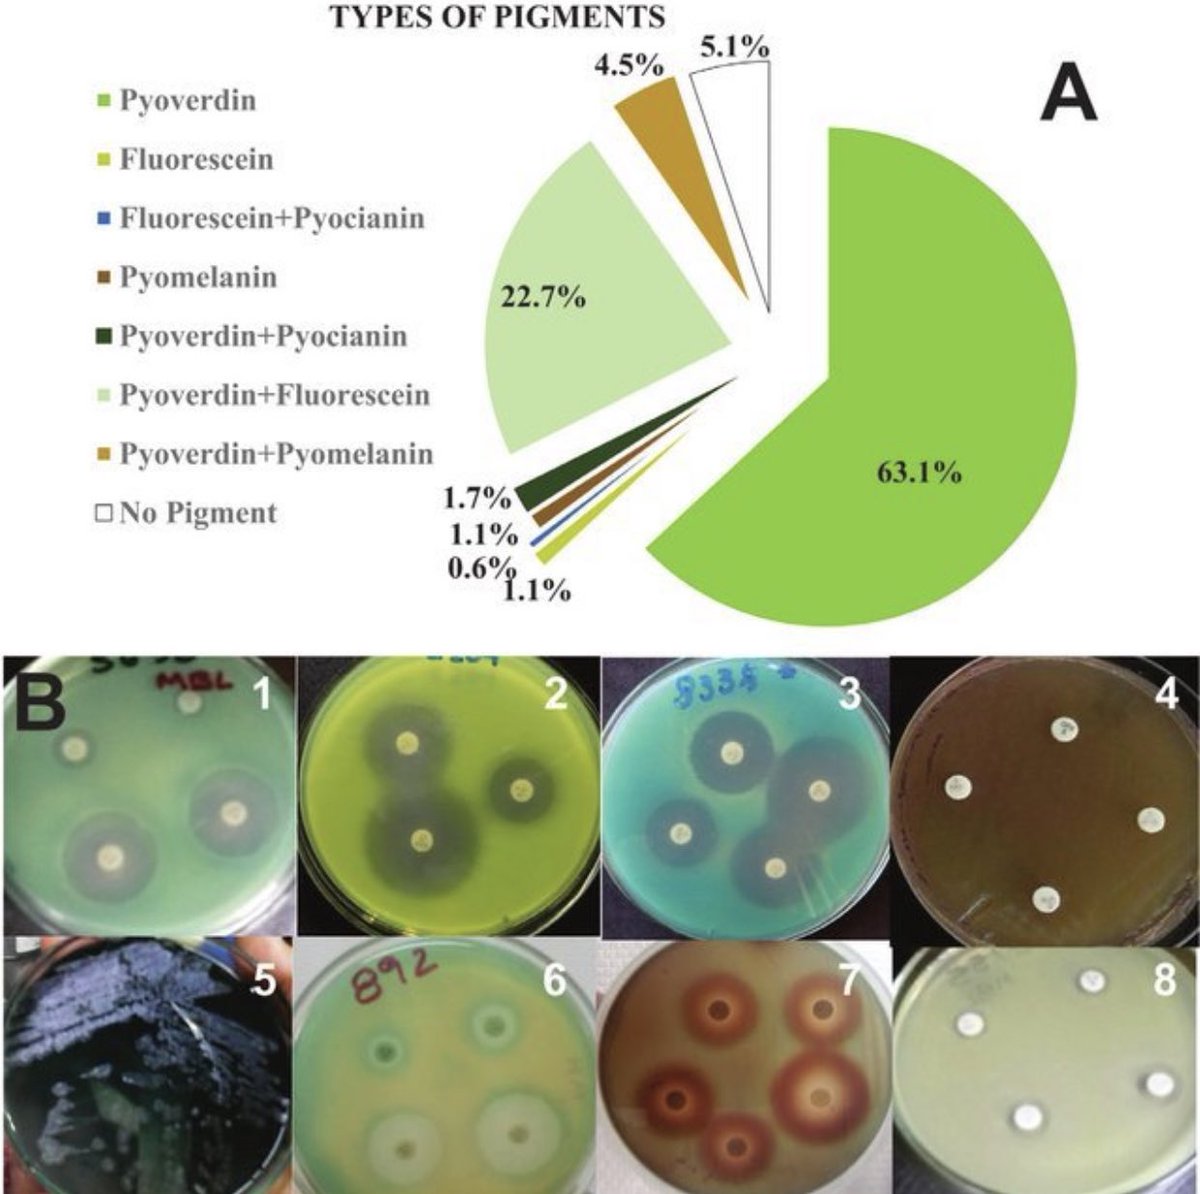

٤/٣
من أهم مميزات هذه الصبغات:
١.سهولة تعريف سلالة البكتريا المفرزة للصبغات من خلال اللون والرائحة.
٢.استخداماتها في مجال الصناعة
٣.استخداماتها في مجال التقنية الحيوية
٤. استخداماتها في مجال صناعة الأدوية
٥. استخداماتها في مجال الأغذية مثل الملونات
من أهم مميزات هذه الصبغات:
١.سهولة تعريف سلالة البكتريا المفرزة للصبغات من خلال اللون والرائحة.
٢.استخداماتها في مجال الصناعة
٣.استخداماتها في مجال التقنية الحيوية
٤. استخداماتها في مجال صناعة الأدوية
٥. استخداماتها في مجال الأغذية مثل الملونات
٤/٤
مؤخرا أثبتت الأبحاث العلمية والدراسات أن لهذه الصبغات نشاط مشابه للمضادات الحيوية وتأثيرها على البكتريا المقاومة للمضادات الحيوية ومازالت تحت الدراسة
مؤخرا أثبتت الأبحاث العلمية والدراسات أن لهذه الصبغات نشاط مشابه للمضادات الحيوية وتأثيرها على البكتريا المقاومة للمضادات الحيوية ومازالت تحت الدراسة
جاري تحميل الاقتراحات...